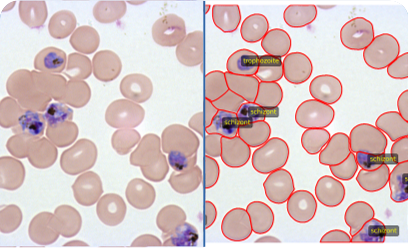
Malaria-Infected Cell Identification

Automate your microscopy workflows with transformer-enhanced deep learning.
Start a project, drag-and-drop your microscopy images, and organize your files.
Our AI model performs instant segmentation, generating masks and object metrics.
Review overlays, refine with manual edits, and add annotations.
Download results—masks, overlays, and tables—for analysis and reporting.

We're here to simplify your workflow. Let us develop a solution for your application.